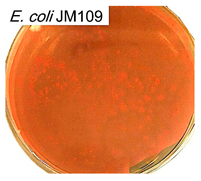
Polymers 17 00065 i006
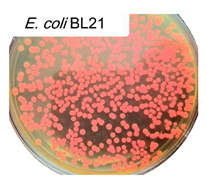
Polymers 17 00065 i009
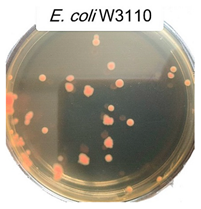
Polymers 17 00065 i012
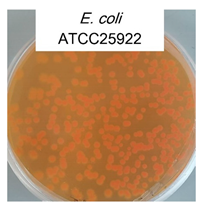
Polymers 17 00065 i015

Optical Methods for Determining the Phagocytic Activity Profile of CD206-Positive Macrophages Extracted from Bronchoalveolar Lavage by Specific Mannosylated Polymeric Ligands
Abstract
1. Introduction
2. Materials and Methods
2.1. Reagents
2.2. Synthesis and Characterization of Ligands for Macrophage CD206 Receptors
2.2.1. Trimannoside-PEG—Trapping Ligand
2.2.2. HPCD-PEI-triMan-FITC—Imaging Ligand
2.2.3. Characterization of Ligands
2.2.4. Determination of Ligand Affinity to Model Mannose Receptor Concanavalin A
2.2.5. Determination of Ligand Affinity to CD206+ by Macrophage Using Cytometry
2.3. Bronchoalveolar Lavage Fluid (BALF) Isolation and Studies
2.3.1. The Origin of BALF
2.3.2. CD206+ Macrophage Extraction
2.3.3. The Cultivation of a Reference Line for Activated CD206+ Macrophages
2.3.4. Confirmation of Macrophage Polarization and CD206 Expression
2.3.5. FTIR-Mapping of the CD206+ Macrophages
2.4. Microbiology Experiments
2.4.1. Bacterial Cells’ Cultivation
- BL21(DE3) CGSC#12504 (F-, lon-11, Δ(ompT-nfrA)885, Δ(galM-ybhJ)884, λDE3 [lacI, lacUV5-T7 gene 1, ind1, sam7, nin5], Δ46, [mal+]K-12(λS), hsdS10) [46];
- JM109 (F+ Δ(lac-proAB), recA1, endA1, gyrA96, thi-1, hsdR17, supE44, relA1, [F’, traD36, proAB, lacIq Z ΔM15] [47];
- MH-1 ΔrecA (F- araD139, Δlac X74, galU, galK, hsdR2, rpsL ΔrecA srl::Tn10) is a derivative of MH-1 that contains the ΔrecA deletion and the Tn10 insertion [48];
- ATCC 25922 from the National Resource Center Russian Collection of Industrial Microorganisms, SIC “Kurchatov Institute”.
2.4.2. Transformation of Bacterial Cells by pRed Plasmid
2.4.3. Visualization of Petri Dishes with E. coli Expressing RFP
2.4.4. Fluorescence Spectroscopy
2.5. Incubation of Macrophages with E. coli
2.5.1. Kinetic Curves of E. coli Phagocytosis
2.5.2. CLSM Visualization of Phagocytosis
2.6. Profiling of the Phagocytic Activity of Macrophages from BALF in Relation to the Clinical Diagnosis
3. Results and Discussion
3.1. Work Design
- The cultivation of the E. coli bacterial strains MH-1, JM109, BL21, W3110, and ATCC25922, the L. fermentum strain and the B. subtilis ATCC6633 strain differed in origin, surface morphology and antibiotic resistance. Each bacterial strain expresses red fluorescent protein (RFP) to visualize phagocytosis by fluorescent methods;
- A spectral analysis of the fluorescent properties of the cultivated strains, along with the acquisition of confocal and electron microscopic images, was conducted;
- By employing the highly specific polymer ligands we have developed, which exhibit a strong affinity for activated macrophages bearing the CD206 mannose receptor, we are able to isolate CD206+ macrophages from the BALF using highly specific mannose-functionalized “trapping ligands”;
- An investigation of the phagocytosis kinetics of E. coli strains by macrophages, depending on the strain phenotype in the presence or absence of a Lactobacilli competitor, was conducted. A comparison was made with the reference model macrophage cell culture;
- A visualization of the E. coli bacteria’s phagocytosis by macrophages, depending on the strain specificity and the presence of Lactobacilli competitors, was performed;
- Profiling of the phagocytic activity of macrophages from BALF in relation to the clinical diagnosis using various bacterial cells (the E. coli strain W3110, the L. fermentum strain and the B. subtilis ATCC6633 strain) was conducted.
3.2. The Characterization of Escherichia coli Strains
3.3. Fluorescence Properties of Escherichia coli Strains Expressing RFP and Lactobacilli Labelled with MB
3.4. Highly Specific Ligands for the Isolation and Characterization of CD206+ Macrophages from Biological Fluids
3.5. The Isolation and Characterization of CD206+ Macrophages from BALF
3.6. Binding of CD206+ Macrophages Derived from BALF to Escherichia coli Cells
3.7. Confocal Laser Scanning Microscopy for Visualization of CD206+ Macrophages from BALF Phagocyted Escherichia coli Cells
3.7.1. Comparison of the Phagocytosis for BALF Macrophages in Comparison with Model CD206+ Macrophages’ Cell Lines
3.7.2. Phagocytic Activity of CD206+ Macrophages from BALF Towards Different Strains of E. coli Cells
- (1)
- The binding ability (according to fluorimetry) of macrophages from the BALF against E. coli strains increases in the order of MH-1 < JM109 ≈ BL-21 < W3110 <≈ ATCC25922, which is correlated with the resistance of bacteria, expressed in terms of the minimum inhibitory concentration of the antibiotics;
- (2)
- The phagocytic ability (according to CLSM) of macrophages from the BALF against E. coli strains increases in the order of BL-21 ≈ W3110 < ATCC25922 << MH-1 ≈ JM109, which is correlated with the presence of pili and/or fimbriae in bacteria.
3.8. Relationship Between Diagnosis and Phagocytic Activity of Macrophages
4. Conclusions
Supplementary Materials
Author Contributions
Funding
Institutional Review Board Statement
Data Availability Statement
Acknowledgments
Conflicts of Interest
References
- Valledor, A.F.; Comalada, M.; Santamaría-Babi, L.F.; Lloberas, J.; Celada, A. Macrophage Proinflammatory Activation and Deactivation. A Question of Balance. Adv. Immunol. 2010, 108, 1–20. [Google Scholar] [CrossRef]
- Vyas, S.P.; Khatri, K. Liposome-based drug delivery to alveolar macrophages. Expert. Opin. Drug Deliv. 2007, 4, 95–99. [Google Scholar] [CrossRef]
- Azad, A.K.; Rajaram, M.V.S.; Schlesinger, L.S. Exploitation of the Macrophage Mannose Receptor (CD206) in Infectious Disease Diagnostics and Therapeutics. J. Cytol. Mol. Biol. 2014, 1, 1000003. [Google Scholar] [CrossRef]
- Liang, T.; Zhang, R.; Liu, X.; Ding, Q.; Wu, S.; Li, C.; Lin, Y.; Ye, Y.; Zhong, Z.; Zhou, M. Recent Advances in Macrophage-Mediated Drug Delivery Systems. Int. J. Nanomed. 2021, 16, 2703–2714. [Google Scholar] [CrossRef]
- Cassetta, L.; Pollard, J.W. Repolarizing macrophages improves breast cancer therapy. Cell Res. 2017, 27, 963–964. [Google Scholar] [CrossRef] [PubMed]
- Epelman, S.; Lavine, K.J.; Randolph, G.J. Origin and Functions of Tissue Macrophages. Immunity 2014, 41, 21–35. [Google Scholar] [CrossRef] [PubMed]
- Yona, S.; Kim, K.W.; Wolf, Y.; Mildner, A.; Varol, D.; Breker, M.; Strauss-Ayali, D.; Viukov, S.; Guilliams, M.; Misharin, A.; et al. Fate Mapping Reveals Origins and Dynamics of Monocytes and Tissue Macrophages Under Homeostasis. Immunity 2013, 38, 79–91. [Google Scholar] [CrossRef] [PubMed]
- Nandakumar, V.; Hebrink, D.; Jenson, P.; Kottom, T.; Limper, A.H. Differential macrophage polarization from Pneumocystis in immunocompetent and immunosuppressed hosts: Potential adjunctive therapy during pneumonia. Infect. Immun. 2017, 85, e00939-16. [Google Scholar] [CrossRef] [PubMed]
- Ying, W.; Cheruku, P.S.; Bazer, F.W.; Safe, S.H.; Zhou, B. Investigation of macrophage polarization using bone marrow derived macrophages. J. Vis. Exp. 2013, 76, e50323. [Google Scholar] [CrossRef]
- Draijer, C.; Robbe, P.; Boorsma, C.E.; Hylkema, M.N.; Melgert, B.N. Characterization of macrophage phenotypes in three murine models of house-dust-mite-induced asthma. Mediat. Inflamm. 2013, 2013, 632049. [Google Scholar] [CrossRef] [PubMed]
- Maev, I.V.; Lyamina, S.V.; Malysheva, E.V.; Yurenev, G.L.; Malyshev, I.Y. An immune response and an alveolar macrophage phenotype in asthma, gastroesophageal reflux disease and their concurrence. Ter. Arkhiv 2015, 87, 34–41. [Google Scholar] [CrossRef]
- Fraternale, A.; Brundu, S.; Magnani, M. Polarization and Repolarization of Macrophages. J. Clin. Cell. Immunol. 2015, 6, 2. [Google Scholar] [CrossRef]
- Porta, C.; Riboldi, E.; Totaro, M.G.; Strauss, L.; Sica, A.; Mantovani, A. Macrophages in cancer and infectious diseases: The “good” and the “bad”. Immunotherapy 2011, 3, 1185–1202. [Google Scholar] [CrossRef] [PubMed]
- Savchenko, I.V.; Zlotnikov, I.D.; Kudryashova, E.V. Biomimetic Systems Involving Macrophages and Their Potential for Targeted Drug Delivery. Biomimetics 2023, 8, 543. [Google Scholar] [CrossRef]
- Hong, J.Y.; Chung, Y.; Steenrod, J.; Chen, Q.; Lei, J.; Comstock, A.T.; Goldsmith, A.M.; Bentley, J.K.; Sajjan, U.S.; Hershenson, M.B. Macrophage activation state determines the response to rhinovirus infection in a mouse model of allergic asthma. Respir. Res. 2014, 15, 63. [Google Scholar] [CrossRef] [PubMed]
- Staples, K.J.; Hinks, T.S.C.; Ward, J.A.; Gunn, V.; Smith, C.; Djukanović, R. Phenotypic characterization of lung macrophages in asthmatic patients: Overexpression of CCL17. J. Allergy Clin. Immunol. 2012, 130, 1404–1412.e7. [Google Scholar] [CrossRef]
- Ruan, G.X.; Chen, Y.Z.; Yao, X.L.; Du, A.; Tang, G.P.; Shen, Y.Q.; Tabata, Y.; Gao, J.Q. Macrophage mannose receptor-specific gene delivery vehicle for macrophage engineering. Acta Biomater. 2014, 10, 1847–1855. [Google Scholar] [CrossRef] [PubMed]
- Di Benedetto, P.; Ruscitti, P.; Vadasz, Z.; Toubi, E.; Giacomelli, R. Macrophages with regulatory functions, a possible new therapeutic perspective in autoimmune diseases. Autoimmun. Rev. 2019, 18, 102369. [Google Scholar] [CrossRef] [PubMed]
- Sharma, N.; Akkoyunlu, M.; Rabin, R.L. Macrophages—Common culprit in obesity and asthma. Allergy Eur. J. Allergy Clin. Immunol. 2018, 73, 1196–1205. [Google Scholar] [CrossRef] [PubMed]
- Kelly, C.; Jefferies, C.; Cryan, S.-A. Targeted Liposomal Drug Delivery to Monocytes and Macrophages. J. Drug Deliv. 2011, 2011, 727241. [Google Scholar] [CrossRef]
- Kurynina, A.V.; Erokhina, M.V.; Makarevich, O.A.; Sysoeva, V.Y.; Lepekha, L.N.; Kuznetsov, S.A.; Onishchenko, G.E. Plasticity of Human THP–1 Cell Phagocytic Activity During Macrophagic Differentiation. Biochemistry 2018, 83, 200–214. [Google Scholar] [CrossRef] [PubMed]
- Kaku, Y.; Imaoka, H.; Morimatsu, Y.; Komohara, Y.; Ohnishi, K.; Oda, H.; Takenaka, S.; Matsuoka, M.; Kawayama, T.; Takeya, M.; et al. Overexpression of CD163, CD204 and CD206 on alveolar macrophages in the lungs of patients with severe chronic obstructive pulmonary disease. PLoS ONE 2014, 9, e87400. [Google Scholar] [CrossRef] [PubMed]
- Kunz, L.I.Z.; Lapperre, T.S.; Snoeck-Stroband, J.B.; Budulac, S.E.; Timens, W.; van Wijngaarden, S.; Schrumpf, J.A.; Rabe, K.F.; Postma, D.S.; Sterk, P.J.; et al. Smoking status and anti-inflammatory macrophages in bronchoalveolar lavage and induced sputum in COPD. Respir. Res. 2011, 12, 34. [Google Scholar] [CrossRef]
- Kim, G.; Park, C.; Yoon, Y.K.; Park, D.; Lee, J.E.; Lee, D.; Sun, P.; Park, S.; Yun, C.; Kang, D.H.; et al. Prediction of lung cancer using novel biomarkers based on microbiome profiling of bronchoalveolar lavage fluid. Sci. Rep. 2024, 14, 1691. [Google Scholar] [CrossRef] [PubMed]
- Kasai, T.; Fukushima, S. Exposure of Rats to Multi-Walled Carbon Nanotubes: Correlation of Inhalation Exposure to Lung Burden, Bronchoalveolar Lavage Fluid Findings, and Lung Morphology. Nanomaterials 2023, 13, 2598. [Google Scholar] [CrossRef] [PubMed]
- Mönki, J.; Holopainen, M.; Ruhanen, H.; Karikoski, N.; Käkelä, R.; Mykkänen, A. Lipid species profiling of bronchoalveolar lavage fluid cells of horses housed on two different bedding materials. Sci. Rep. 2023, 13, 21778. [Google Scholar] [CrossRef] [PubMed]
- Qiaozhen, H.; Jifei, Z.; Lingrong, H.; Qiuming, Y.; Hongjuan, Y.; Qiaozhen, H. Clinical significance of detection of mononuclear phagocyte subsets in blood and bronchoalveolar lavage fluid (BALF) in pulmonary sarcoidosis. Cell. Mol. Biol. 2021, 67, 109–116. [Google Scholar] [CrossRef] [PubMed]
- Li, J.; Wang, T.; Liu, F.; Wang, J.; Qiu, X.; Zhang, J. Diagnostic test accuracy of cellular analysis of bronchoalveolar lavage fluid in distinguishing pulmonary infectious and non-infectious diseases in patients with pulmonary shadow. Front. Med. 2024, 11, 1496088. [Google Scholar] [CrossRef] [PubMed]
- Hogea, S.P.; Tudorache, E.; Pescaru, C.; Marc, M.; Oancea, C. Bronchoalveolar lavage: Role in the evaluation of pulmonary interstitial disease. Expert Rev. Respir. Med. 2020, 14, 1117–1130. [Google Scholar] [CrossRef] [PubMed]
- Ren, J.; Chen, W.; Zhong, Z.; Wang, N.; Chen, X.; Yang, H.; Li, J.; Tang, P.; Fan, Y.; Lin, F.; et al. Bronchoalveolar Lavage Fluid from Chronic Obstructive Pulmonary Disease Patients Increases Neutrophil Chemotaxis Measured by a Microfluidic Platform. Micromachines 2023, 14, 1740. [Google Scholar] [CrossRef] [PubMed]
- Hwang, J.; Brezhnev, D.; Shitanishi, L.; Chen, P.; Rampolla, R.; Zaffiri, L. Bronchoalveolar Lavage Fluid Eosinophilia Associated with Worse Outcomes After Lung Transplant. J. Heart Lung Transplant. 2024, 43, S301–S302. [Google Scholar] [CrossRef]
- Zlotnikov, I.D.; Kudryashova, E.V. Biomimetic System Based on Reconstituted Macrophage Membranes for Analyzing and Selection of Higher-Affinity Ligands Specific to Mannose Receptor to Develop the Macrophage-Focused Medicines. Biomedicines 2023, 11, 2769. [Google Scholar] [CrossRef] [PubMed]
- Zlotnikov, I.D.; Vigovskiy, M.A.; Davydova, M.P.; Danilov, M.R.; Dyachkova, U.D.; Grigorieva, O.A.; Kudryashova, E.V. Mannosylated Systems for Targeted Delivery of Antibacterial Drugs to Activated Macrophages. Int. J. Mol. Sci. 2022, 23, 16144. [Google Scholar] [CrossRef] [PubMed]
- Zlotnikov, I.D.; Kudryashova, E.V. Polymeric Infrared and Fluorescent Probes to Assess Macrophage Diversity in Bronchoalveolar Lavage Fluid of Asthma and Other Pulmonary Disease Patients. Polymers 2024, 16, 3427. [Google Scholar] [CrossRef] [PubMed]
- Knowles, M.R.; Zariwala, M.; Leigh, M. Primary Ciliary Dyskinesia. Clin. Chest Med. 2016, 37, 449–461. [Google Scholar] [CrossRef]
- Oxman, D.A.; Wilck, M.B. Community-Acquired Pneumonia. In Intensive Care Unit Manual, 2nd ed.; Elviser: Amsterdam, The Netherlands, 2013; Volume 362, pp. 622–629.e2. [Google Scholar] [CrossRef]
- Gao, C.A.; Markov, N.S.; Stoeger, T.; Pawlowski, A.; Kang, M.; Nannapaneni, P.; Grant, R.A.; Pickens, C.; Walter, J.M.; Kruser, J.M.; et al. Machine learning links unresolving secondary pneumonia to mortality in patients with severe pneumonia, including COVID-19. J. Clin. Investig. 2023, 133, e170682. [Google Scholar] [CrossRef]
- Kang, Y.P.; Lee, W.J.; Hong, J.Y.; Lee, S.B.; Park, J.H.; Kim, D.; Park, S.; Park, C.S.; Park, S.W.; Kwon, S.W. Novel approach for analysis of bronchoalveolar lavage fluid (BALF) using HPLC-QTOF-MS-based lipidomics: Lipid levels in asthmatics and corticosteroid-treated asthmatic patients. J. Proteome Res. 2014, 13, 3919–3929. [Google Scholar] [CrossRef] [PubMed]
- Tokunaga, Y.; Imaoka, H.; Kaku, Y.; Kawayama, T.; Hoshino, T. The significance of CD163-expressing macrophages in asthma. Ann. Allergy Asthma Immunol. 2019, 123, 263–270. [Google Scholar] [CrossRef]
- St-Laurent, J.; Turmel, V.; Boulet, L.P.; Bissonnette, E. Alveolar macrophage subpopulations in bronchoalveolar lavage and induced sputum of asthmatic and control subjects. J. Asthma 2009, 46, 1–8. [Google Scholar] [CrossRef]
- Zlotnikov, I.D.; Kudryashova, E.V. Spectroscopy Approach for Highly-Efficient Screening of Lectin-Ligand Interactions in Application for Mannose Receptor and Molecular Containers for Antibacterial Drugs. Pharmaceuticals 2022, 15, 625. [Google Scholar] [CrossRef] [PubMed]
- Zlotnikov, I.D.; Ezhov, A.A.; Ferberg, A.S.; Krylov, S.S.; Semenova, M.N.; Semenov, V.V.; Kudryashova, E.V. Polymeric Micelles Formulation of Combretastatin Derivatives with Enhanced Solubility, Cytostatic Activity and Selectivity against Cancer Cells. Pharmaceutics 2023, 15, 1613. [Google Scholar] [CrossRef] [PubMed]
- Zlotnikov, I.D.; Streltsov, D.A.; Belogurova, N.G.; Kudryashova, E.V. Chitosan or Cyclodextrin Grafted with Oleic Acid Self-Assemble into Stabilized Polymeric Micelles with Potential of Drug Carriers. Life 2023, 13, 446. [Google Scholar] [CrossRef]
- Zlotnikov, I.D.; Ezhov, A.A.; Petrov, R.A.; Vigovskiy, M.A.; Grigorieva, O.A.; Belogurova, N.G.; Kudryashova, E.V. Mannosylated Polymeric Ligands for Targeted Delivery of Antibacterials and Their Adjuvants to Macrophages for the Enhancement of the Drug Efficiency. Pharmaceuticals 2022, 15, 1172. [Google Scholar] [CrossRef] [PubMed]
- Bachmann, B.J. Pedigrees of some mutant strains of Escherichia coli K-12. Bacteriol. Rev. 1972, 36, 525–557. [Google Scholar] [CrossRef] [PubMed]
- William Studier, F.; Rosenberg, A.H.; Dunn, J.J.; Dubendorff, J.W. Use of T7 RNA polymerase to direct expression of cloned genes. Methods Enzymol. 1990, 24, 60–89. [Google Scholar]
- Yanisch-Perron, C.; Vieira, J.; Messing, J. Improved M13 phage cloning vectors and host strains: Nucleotide sequences of the M13mpl8 and pUC19 vectors. Gene 1985, 33, 103–119. [Google Scholar] [CrossRef]
- Goddard, J.M.; Caput, D.; Williams, S.R.; Martin, D.W. Cloning of human purine-nucleoside phosphorylase cDNA sequences by complementation in Escherichia coli. Proc. Natl. Acad. Sci. USA 1983, 80, 4281–4285. [Google Scholar] [CrossRef] [PubMed]
- Matz, M.V.; Fradkov, A.F.; Labas, Y.A.; Savitsky, A.P.; Zaraisky, A.G.; Markelov, M.L.; Lukyanov, S.A. Fluorescent proteins from nonbioluminescent Anthozoa species. Nat. Biotechnol. 1999, 17, 969–973. [Google Scholar] [CrossRef]
- Maniatis, T.; Fritsch, E.F.; Sambrook, J. Molecular Cloning: A Laboratory Manual; Cold Spring Harbor Laboratory Press: Cold Spring Harbor, NY, USA, 1983; Volume 58. [Google Scholar]
- Wu, G.; Ding, J.; Li, H.; Li, L.; Zhao, R.; Shen, Z.; Fan, X.; Xi, T. Effects of cations and PH on antimicrobial activity of thanatin and s-thanatin against Escherichia coli ATCC25922 and B. subtilis ATCC 21332. Curr. Microbiol. 2008, 57, 552–557. [Google Scholar] [CrossRef]
- He, M.; Wu, T.; Pan, S.; Xu, X. Antimicrobial mechanism of flavonoids against Escherichia coli ATCC 25922 by model membrane study. Appl. Surf. Sci. 2014, 305, 515–521. [Google Scholar] [CrossRef]
- Stenström, T.A.; Kjelleberg, S. Fimbriae mediated nonspecific adhesion of Salmonella typhimurium to mineral particles. Arch. Microbiol. 1985, 143, 6–10. [Google Scholar] [CrossRef]
- Otto, K.; Elwing, H.; Hermansson, M. The role of type 1 fimbriae in adhesion of Escherichia coli to hydrophilic and hydrophobic surfaces. Colloids Surf. B Biointerfaces 1999, 15, 99–111. [Google Scholar] [CrossRef]
- Chao, Y.; Zhang, T. Probing roles of lipopolysaccharide, type 1 fimbria, and colanic acid in the attachment of Escherichia coli strains on inert surfaces. Langmuir 2011, 27, 11545–11553. [Google Scholar] [CrossRef]










| Strain Expressing RFP | RFP Confocal Fluorescence Image | TEM Image | Photos of Colonies Grown on Agar Plates | MIC(LF), mg/L |
|---|---|---|---|---|
| E. coli MH-1 | ![]() | ![]() | ![]() | 0.10 ± 0.02 |
| E. coli JM109 | ![]() | ![]() | ![]() | 1.0 ± 0.1 |
| E. coli BL21 | ![]() | ![]() | ![]() | 1.4 ± 0.2 |
| E. coli W3110 | ![]() | ![]() | ![]() | 1.8 ± 0.2 |
| E. coli ATCC25922 | ![]() | ![]() | ![]() | 2.4 ± 0.3 |
| Ligand | Chemical Designation | Polymer | Molecular Weight of Ligand, kDa | Hydrodynamic Size *, nm | ζ-Potential **, mV | Kdis (ConA–Ligand), M *** | % of FITC-Labelled CD206+ Macrophages **** |
|---|---|---|---|---|---|---|---|
| Trapping | trimannoside-PEG (1:1 mol/mol) | PEG 5 kDa | 6 ± 1 | 90 ± 10 | +1.5 ± 0.5 | (8 ± 1) × 10−7 | 73 ± 2 |
| Imaging | HPCD-PEI-trimannoside-FITC (2:1:0.5:5 by mol) | PEI 2 kDa | 9.7 ± 1.5 | 115 ± 20 | +7 ± 1 | (2.5 ± 0.5) × 10−7 | 80 ± 4 |
| Without Lactobacilli competitor | |||||
| Strain | E. coli MH-1 | E. coli JM109 | E. coli BL21 | E. coli W3110 | E. coli ATCC25922 |
| E. coli adsorbed and absorbed by macrophages in 2 h, % (from added) | 11 ± 1 | 14 ± 2 | 14 ± 1 | 19 ± 2 | 20 ± 2 |
| The initial rate of E. coli binding, %/min | 5.0 ± 0.5 | 3.7 ± 0.8 | 4.3 ± 0.6 | 4.5 ± 0.5 | 5.1 ± 0.7 |
| Lactobacilli competitor | |||||
| Strain | E. coli MH-1 | E. coli JM109 | E. coli BL21 | E. coli W3110 | E. coli ATCC25922 |
| E. coli adsorbed and absorbed by macrophages in 2 h, % (from added) | 10 ± 1 | 11 ± 1 | 10 ± 1 | 11 ± 1 | 14 ± 2 |
| The initial rate of E. coli binding, %/min | 4.1 ± 0.3 | 4.7 ± 0.4 | 1.4 ± 0.1 | 1.5 ± 0.2 | 4.4 ± 0.8 |
Disclaimer/Publisher’s Note: The statements, opinions and data contained in all publications are solely those of the individual author(s) and contributor(s) and not of MDPI and/or the editor(s). MDPI and/or the editor(s) disclaim responsibility for any injury to people or property resulting from any ideas, methods, instructions or products referred to in the content. |
© 2024 by the authors. Licensee MDPI, Basel, Switzerland. This article is an open access article distributed under the terms and conditions of the Creative Commons Attribution (CC BY) license (https://creativecommons.org/licenses/by/4.0/).
Share and Cite
Zlotnikov, I.D.; Ezhov, A.A.; Kolganova, N.I.; Ovsyannikov, D.Y.; Belogurova, N.G.; Kudryashova, E.V. Optical Methods for Determining the Phagocytic Activity Profile of CD206-Positive Macrophages Extracted from Bronchoalveolar Lavage by Specific Mannosylated Polymeric Ligands. Polymers 2025, 17, 65. https://doi.org/10.3390/polym17010065
Zlotnikov ID, Ezhov AA, Kolganova NI, Ovsyannikov DY, Belogurova NG, Kudryashova EV. Optical Methods for Determining the Phagocytic Activity Profile of CD206-Positive Macrophages Extracted from Bronchoalveolar Lavage by Specific Mannosylated Polymeric Ligands. Polymers. 2025; 17(1):65. https://doi.org/10.3390/polym17010065
Chicago/Turabian StyleZlotnikov, Igor D., Alexander A. Ezhov, Natalia I. Kolganova, Dmitry Yurievich Ovsyannikov, Natalya G. Belogurova, and Elena V. Kudryashova. 2025. "Optical Methods for Determining the Phagocytic Activity Profile of CD206-Positive Macrophages Extracted from Bronchoalveolar Lavage by Specific Mannosylated Polymeric Ligands" Polymers 17, no. 1: 65. https://doi.org/10.3390/polym17010065
APA StyleZlotnikov, I. D., Ezhov, A. A., Kolganova, N. I., Ovsyannikov, D. Y., Belogurova, N. G., & Kudryashova, E. V. (2025). Optical Methods for Determining the Phagocytic Activity Profile of CD206-Positive Macrophages Extracted from Bronchoalveolar Lavage by Specific Mannosylated Polymeric Ligands. Polymers, 17(1), 65. https://doi.org/10.3390/polym17010065